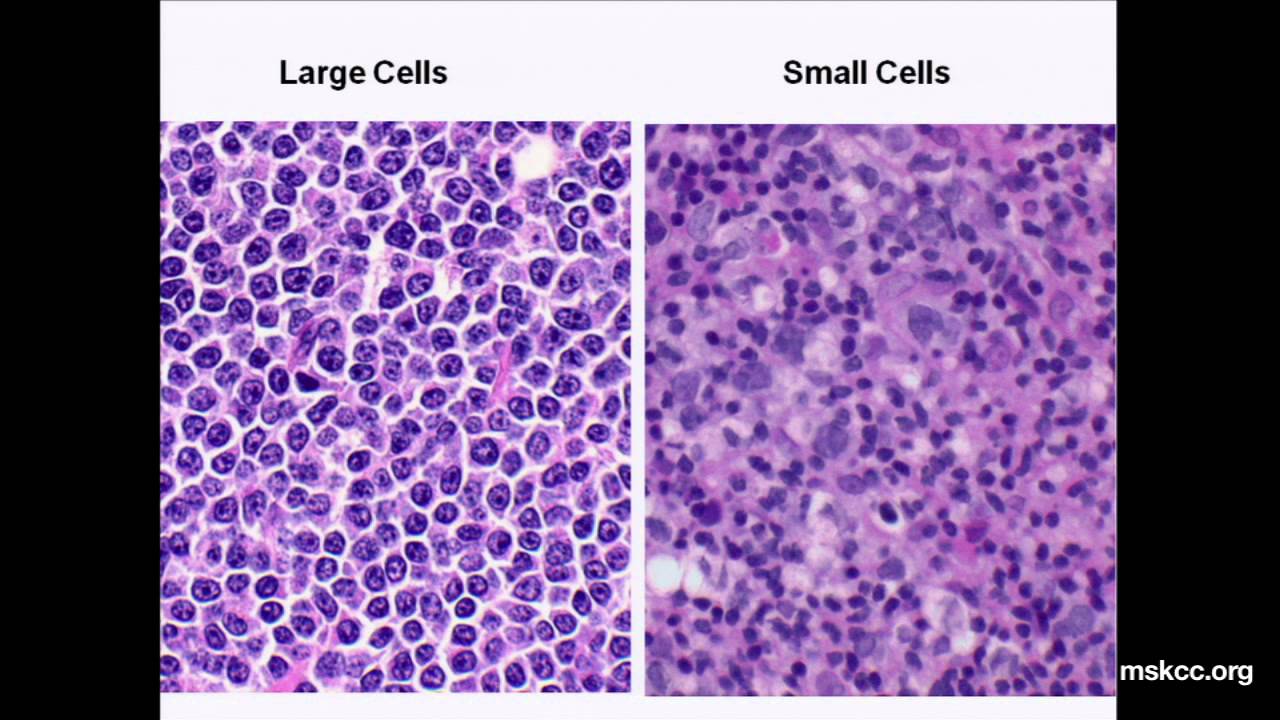
What You Need to Know about Non-Hodgkin's Lymphoma: Presentation

Foreign engineers in this video today we're going to be talking about Non-Hodgkin's lymphoma before we get started if you guys like this video If it makes sense please support us one of the ways that you guys can do that is by hitting the like button commenting down the comment section or subscribing please try to do that if you can also if you guys want some amazing notes some awesome Illustrations that our team has whipped up together for you guys to follow along with me during this lecture go down in the description box below there's a
link to our website you'll find all that there but let's talk about Non-Hodgkin's lymphoma if you guys haven't already I would suggest that you watch the Hodgkin's lymphoma first before watching this lecture I just think that that really Builds on the base of what we're going to talk about and then we're going To kind of recap a couple things talk about a lot of similarities but also the differences between them so first things first when we talk about lymphoma in general it's an abnormality within the lymphocyte pathway right so we have to quickly go over
kind of how lymphocytes are formed how they mature where they go all the different kind of phases that they'll move through throughout the lymph node then we'll talk about is the different types of Non-Hodgkin's lymphoma so if you guys remember in Hodgkin's lymphoma it was weird there's not a ton of evidence but there's a thought process that at some point in the lymphocyte development at least it's in the germinal center whether it's at the central blast stage or the centrocyte stage it's supposed to undergo apoptosis but it doesn't and it was because of the increase
in the nuclear Factor Kappa beta from EBV or HIV or immunosuppressed States And Non-Hodgkin's lymphoma there's different types of B cell lymphones which is the most common type of Non-Hodgkin's lymphomas the B cell type Non-Hodgkin's lymphoma and there's various different stages so that's where there is a big difference between Hodgkin's and Non-Hodgkin's Non-Hodgkin's has a lot of different types of Non-Hodgkin's lymphoma particularly of the B cell flavor so let's go over first the lymphocyte Pathway just kind of get an understanding of it and then what we'll do is we'll dive into it a little bit
more into the types the causes a lot of genetics that are involved in this so the first thing that we have to start off with is that all like white blood cells are produced in the red bone marrow right so we start off in What's called the red bone marrow and in the red bone marrow you start what's called a hematocytal Hemocytoplast or a pluripotent stem cell and that's supposed to differentiate and it differentiates into two different types of cells one is a myeloid stem cell which will make your you know granulocytes your red blood
cells your platelets and the lymphoid stem cell the lymphoid stem cell is the one that makes lymphocytes so that's this one here the lymphoid stem cell then what happens is the lymphoid stem cell will become two different types of lymphocytes like kind Of one is it's going to become what's called a precursor T Cell so Paul is a precursor T cell and then here we're going to have a B cell but this is called a precursor B cell now the precursor T cell is going to be very naive it doesn't really know what it wants
to be when it grows up okay so it has to go to the thymus the thymus has a lot of different thymic cells and B cells there that are going to help to mature and Differentiate these naive or precursor T cells into functional T cells and it comes out of the thymus with two particular types of cells one is it can become a T cell that expresses a very specific type of protein on its surface and what are those let's say here in blue we crawl we have this protein here and then here in red
we'll have this other protein and this is really what kind of differentiates the T cells so here in blue we're going to have What's Called the CD4 positive proteins and here in red we'll have the cd8 positive proteins and this will kind of determine which types of cells we have if it's CD4 positive we call this T helper cells so we call these T helper cells if it's the cd8 it's primarily cytotoxic T cells so that's kind of the big difference now what happens is these cells they can move through the blood but also collectively
they can go and kind of Infiltrate into the lymph node and stay in the lymph node now when we talked about Hodgkin's lymphoma we didn't discuss anything about T cell types of Hodgkin's lymphoma we said it was primarily B cell in Non-Hodgkin's lymphoma it is primarily B cell types of Non-Hodgkin's lymphoma but there's very few cases very few and we're going to briefly talk about it here in which you can have what's called a t Cell Non-Hodgkin's lymphoma this accounts for maybe 10 to 15 percent of the Non-Hodgkin's lymphoma 85 to like you know pretty
much 90 of the actual cases of Non-Hodgkin's are B cell which will spend most of the time talking about but of these there is some type of problematic issue when these cells are supposed to come here these T cells are supposed to come here and kind of lay their groundwork here in The lymph node they undergo some type of mutation process and when they undergo this type of mutation they can end up kind of replicating and proliferating some way in shape or form in the lymph nodes in the blood and in the skin tissues those
are the three different areas the blood the lymph nodes and the skin tissues but this type we call T cell lymphoma And the primary cause which is believed to be associated with this since we're already talking about it is believed to be associated with the human T Cell lymphotropic virus for some particular reason it may produce some type of mutation Within These T cells and lymph nodes and cause them to proliferate in some particular way but that's the really really rare one we're not going to spend a ton of time talking about this one we're
going to talk a lot about The B cell types now if you guys remember what happens is this precursor B cell is kind of naive if you will so if we think about it here it's kind of moving through the blood it hasn't been exposed to any type of antigen yet so we can also call this precursor B cell we can call it a naive B cell and what that means it has not been exposed to any antigens yet what happens is it can then move into this particular Zone here right and In one way
maybe it moves into the zone and stays there doesn't get exposed to any antigens or maybe it moves into this Zone and it gets exposed to a particular antigen because you know on these B cell surfaces they have what's called B cell receptors they're like little antibodies and they attach to different antigens that's what happens in this Zone here you know what this zone is called here this Zone here this Zone here is called The mantle Zone it's called the mantle Zone so in this zone is where antigens should generally either be exposed to an
uh whether these B cells either get exposed to an antigen or don't get exposed to an antigen so what I'm going to do is I'm going to kind of put this guy here and I'm going to put on its surface here we're going to have this cell here this is our naive B cell this is our naive B cell They're both going to have these B cell receptors on them they're both going to have these B cell receptors if it gets exposed to an antigen it then becomes a very different type of solid from this
point it says oh I've recognized this antigen with my B cell receptor here it has not if there's antigen exposure then what it does is it says okay I've upgraded I can move into the germinal center of this Lymph node because really what we're doing is we talk about what all is happening here all we're talking about is here's our lymph node here's the efference the afferent lymphatic vessels and you have your traberculae and then really what we're doing is we're looking at this kind of follicle and we're zooming in on it here that's where
all these B cells are infiltrating into When they go into the mantle zone of this they should be exposed to an antigen if they're exposed to an antigen they'll move in here if they don't become exposed to the antigen they kind of just stay in the mantle Zone in this naive phase once they go into the germinal center and they've had antigen exposure so we're going to put this as antigen exposure at this point then it goes in it gets a Little bit bigger it gets a little bit bigger okay and what it does is
at this stage is it starts changing a little bit of its actual B cell receptor so maybe change is one of the variable portions of it a little bit just makes it a little bit different so it combine onto a variety of different types of antigens so what is this big sucker here called This is called a centroblast it's called a Centro blast Now what happens with this Central blast we said first thing you have this naive B cell that either gets exposed to the antigen or it doesn't so it kind of has this like
little bifurcation pathway if it goes here and it stays without any antigen exposure we actually call this a mantle cell lymphocyte okay if it gets exposed to the antigen Then we say hey we can now move this guy into the next stage to become a central blast goes into the germinal center here and then what happens is it kind of changes the little variable regions on the B cell receptor this is called somatic hyper mutation it kind of just changes the variable regions of these B cell receptors a little bit Then what happens is once
this kind of like cell has actually been formed it's performed sabbatic hypermutation it should start kind of dividing so it should do something called clonal expansion and what it'll do is it'll kind of start kind of dividing and making a ton of more Central blasts so here we're going to have a ton of central blasts that are being formed ton of central blasts that are being Formed here with all these different types of variable B cell receptors on them now here's the next thing that happens at this stage these Central blasts if they express these
B cell receptors with their variable region they should have to go and recognize antigens and if they have a strong affinity for antigens that's good if they have no affinity for any particular type of antigen that's bad And they should probably undergo apoptosis so that's where we kind of diverge this pathway a little bit and we take it here to where they may go in two different parts one is that the cell may have to undergo apoptosis because it has no affinity for the proper antigen so it won't do its job very well okay so
this means a low affinity for the antigen Okay it's not a good somatic hypermutation it's not a good cell that we want if it has good affinity for the antigen then it moves on to the next stage it's passed and the central blast then moves into this next stage here so this is kind of like a weird lobe nucleus but this one's kind of same thing kind of weird load a little bit smaller though This one is called a centrocyte so what is this one called here this one is called a Centro sight now the
centrocyte will have all these like perfect B cell receptors which have good affinity for antigens they've already passed that step of somatic hypermutation they've already you know had good testing for the actual antigen they didn't undergo apoptosis because this is the pathway That they would go if they have poor Affinity they have undergo apoptosis if they do have good Affinity then they go become centrocytes the centrocytes didn't go and interact with other cells so there's some other cells that are supposed to be in the vicinity here so you'll have one cell which is called a
T cell and you'll have another one which is called a dendritic cell and what these are supposed to do is is They're supposed to properly interact with this centrocyte they're supposed to properly interact with the centrocyte and Trigger the centrocyte to decide hey what are you going to become are you going to become a memory B cell are you going to become a plasma cell because you need to figure out this point right here and at this point right here where it decides what it's going to do this is called class Switching and basically all
that means is it kind of determines what kind of antibodies it's going to produce maybe it switches it up to like IGA and IGG Etc types of antibodies so at this point here the T cells and the dendritic cells are really helping with this process of the centrocyte determining this process of class switching and getting ready to differentiate So then once it passes this stage it moves into this Zone here it moves into this Zone here and this Zone here is called the marginal zone so what is this Zone here called This is called the
marginal Zone so these lymphocytes would be the marginal Zone lymphocytes once it moves here it finally will undergo differentiation when it Undergoes this differentiation process it'll turn into two different types of cells if you will one is it'll decide to become a memory B cell or it'll decide to become a plasma cell so from here this marginal zone lymphocyte right here this marginal Zone lymphocyte will decide to become a memory B cell which will have these beautiful little B cell receptors on them which are designed and primed to be able to recognize any type of
foreign antigen Because it has these nice little variable regions on there or to become a cell that produces antibodies that becomes an antibody producing Factory and this will become what's called a Plasma Blast which will then differentiate into a plasma cell and plasma cells are antibody producing factories so they'll produce these antibodies that have the Little kind of like small variable region on them that are primed to be able to recognize any type of foreign antigen my friends this is a lot of stuff and you're probably like okay Zach how how is Non-Hodgkin's lymphoma going
to fit in here don't worry I got you along this pathway we talked about in Hodgkin's lymphoma it was kind of like the central blast and Central sites are being getting stuck into an area where They couldn't die that's what it was in Hodgkin's lymphoma right there's a lot of nuclear Factor Kappa beta it was turning off the apoptosis genes and the cell was just be able to survive without dying in these stages of Non-Hodgkin's lymphoma it occurs at different points so the first one here is you can have basically some type of mutation that
occurs at this point here so we're going to kind of Mark these and we're going to Go down in a second and talk about each one but at this point here if this cell undergoes a particular mutation at this particular point it can cause something called mantle cell lymphoma if there's a mutation at some point here in the centroblast where it undergoes a mutation and continues to keep replicating or not dying this can become different types of lymphomas we'll talk about what's called diffuse large B cell lymphoma and burkitt's Lymphoma And if at this point
the centrocyte there's a mutation that occurs here this can cause something called follicular cell lymphoma or follicular lymphoma and then if there's some type of mutation that occurs in the lymphocytes at the marginal Zone this can cause something called marginal Zone lymphoma so now let's come down for a second and talk about specifically what are these different types and what are the causes of the reasons these things occur It's actually very very interesting so the first thing that I want to talk about here is going to be going over all these different types of neoplastic
lymphocytes the B cell type we already talked about the T cell type it was the rare type that can occur where there's a mutation in the T Cell development as it goes into the lymph node with the human T lymphotropic virus for these ones it's a little bit different so remember quickly here here Was our naive B cell the one that had not been exposed to an antigen here you have antigen exposure if it exposes to the antigen it then moves into the germinal center and becomes a central blast so here's our Centro blast then
it undergoes somatic hypermutation and if it doesn't undergo apoptosis and it survives it then becomes a Central site then the Central site will then differentiate in the zone called the Marginal Zone and then the last thing is it'll actually differentiate and become memory B cells or plasma cells and then really quickly this zone right here we say that when the naive B cell gets exposed to the antigen it then moves from the mantle Zone into the germinal center if there's no antigen exposure it stays here in the mantle zone so this is your mantle cell
At each point here there's mutations so I'm going to talk first about the different types of B cell Non-Hodgkin's lymphoma in a particular way that I think will help you to remember it so we talk about these I put them into two groups one is a group where the cause of them actually having a lot of these neoplastic lymphocytes in the lymph node is decrease cellular apoptosis And the other group here is the reason why they have tons of these neoplastic lymphocytes in their lymph nodes is because the cells are hyper proliferating so the reason
why this is important is because if cells don't die they won't kind of proliferate proliferate proliferate proliferate they'll just live for forever for a really long time but that means that it's not really rapid it's not super aggressive instead This is more of the types of Non-Hodgkin's lymphomas that are more indolent and are slow growing that's a really really important thing whereas if I were to take the situation here with the increased cellular perforation these things are proliferating so quickly that they are rapid and super aggressive so that kind of really helps us to kind
Of delineate the two different types of Non-Hodgkin's lymphomas here into which ones are very slow indolent and which ones are rapid and very aggressive so now here's what we got to do we're gonna have the different stages the first one for the decreased cellular apoptosis for the indolent slow growing Non-Hodgkin's lymphoma is follicular lymphoma and marginal Zone lymphoma so let's come back at What stages would that be so we said here naive B cell Goes into the mantle Zone if it doesn't get exposed to the antigen and it proliferates and replicates and it survives here
it's called marginal Zone lymphoma I'm sorry uh mantles on lymphoma if it goes here becomes a central blast we said any kind of mutations here the central blast would be diffused large B cell lymphoma or would be what else berke's lymphoma if we go to the centrocyte and there's mutations there This gives way to follicular lymphoma and if there's a mutation that occurs in the mantle Zone this gives way to what's called marginal Zone lymphoma so the question then comes okay I know follicular lymphoma is a mutation where these Central sites are surviving and then
there's also marginal Zone lymphoma is basically where the marginal Zone lymphocytes are continuing to survive and not die what are the reasons why They survive and don't undergo apoptosis great question so for liquid lymphoma it's due to a chromosomal translocation the chromosomal translocation in this part is occurring between chromosomes 14 and 18. there is a translocation at this point here what happens is there's a very special Gene that kind of gets hyper activated and you know what this gene is called this Gene is called that actually kind of gets expressed here is What's called the
bcl2 so you're going to hyper activate the expression of this molecule called bcl2 now bcl2 is a very specific molecule that when it's hyper expressed it inhibits apoptosis so the cells won't be able to die so this will inhibit apoptosis and if you inhibit apoptosis you will continue to allow for the cells to Become immortal and live forever and so this basically increases your cell number because they will not die that's one way that follicular lymphoma will occur all right so that's one particular problem a 14 18 translocation increasing the expression of this molecule here
which inhibits apoptosis well I'm guessing the same thing happens here there's no obvious kind of chromosomal translocation but what we do know is That at some point along this structure there's another type of Gene that's hyper expressed and it's another BCL it's BCL 10. so there is a hyper expression of this molecule called bcl10 and guess what bcl10 does it basically increases the expression of nuclear Factor Kappa beta that sounds familiar and if I increase the expression of nuclear Factor Kappa beta what I do is is I remember that Inhibits apoptosis so if I inhibit
apoptosis I allow for the cells to continue to survive so I increase my cell number and the same thing in this particular situation I'll increase my cell number so this is basically how this occurs so for these two different types of Non-Hodgkin's lymphoma that are slow very indolent the follicular lymphoma the marginal Zone lymphoma for follicular it's due to a 14 18 translocation that increased the expression of a bcl2 molecule that will inhibit apoptosis for marginal Zone lymphoma which is basically an increased number of marginal Zone cells in the marginal Zone it's due to an
increase in BCL 10 which inhibits apoptosis okay so that's a really key Point here so now we have knocked out at least at this point here Follicular lymphoma and Marshall Zone lymphoma we now have to knock out the diffuse large B cell the burkets and then the mantle cell lymphoma okay so let's come over here now so if we move over here we move into the next part of this kind of diagram so again just to recap it because it's always good to have kind of like small repetition here here is your naive B cell
here it gets antigen exposure here there Is no antigen exposure if it stays here it's a mantle cell lymphocyte if it goes here after the antigen exposure it becomes a central blast if it undergoes somatic hypermutation and survives it becomes a Central site if it differentiates in this Zone it becomes a marginal Zone lymphocyte and then from here should become a memory B cell or a plasma cell we've already knocked out at this point the centrosite and the marginal zone so Now we have to cover the central blast and this mantle cell there is technically
another one here but we'll briefly discuss it and that's it so now what happens here is we're going to talk about mantle cell which is there's a mutation that occurs at some point within these cells the burkets and diffuse which occurs at some point along these cells and then just to quickly like discuss this I Won't go too crazy but at this point here this cell that does get exposed to antigen I know you guys are probably wondering does something happen to that one it does technically this can lead to the formation of something that
we already talked about chronic lymphocytic lymphoma or small lymphocytic lymphoma but we talked about that already we don't need to go over This that's it that's all I want you to know about this is that if this actual naive B cell gets exposed to an inch and it stays in the actual mantle Zone it gets ready to go into the germinal center if there's a mutation that occurs along that point it can lead to CLL or small lymphocytic lymphoma but if it's here when it doesn't get exposed to an antigen or it actually does it
undergo somatic hypermutation or we already kind of talked about these Points now we have to discuss these so the first one here is we're going to discuss the actual cells in the mantle Zone that did not get exposed to the antigen this is mantle cell lymphoma with mantle cell lymphoma there is a chromosomal translocation and it occurs between chromosomes 11 and 14. and what happens is it increases the activity of a very specific type of Gene and what this Gene does is is it increases the expression of something Called cyclin D if you guys have
watched our video or we talked about um a lot of the actual cellular Pathways and stuff we kind of went over this and basically cycling D what it's been shown to do is it works with like cyclin-dependent kinases this will help cells to go into the S phase so S phase is where you have a lot of DNA replication so this will basically try to trigger cell proliferation that's really all it's Going to try to do it's going to try to increase cell proliferation because it'll help to push this cell into What's called the S
phase quicker and if you increase cellular proliferation you're going to increase your cell number it's just you'll increase your cell number very quickly and rapidly and that will be in a rapid aggressive tumor okay so that's mantle cell lymphoma that's at this point here so if this Cell that does not get exposed to an antigen that's in the mantle Zone becomes mutated at this point this 11 14 translocation increase the expression of cyclin D causes increased cellular proliferation it can cause mantle cell lymphoma if it's of the central blast so here we have mantle cell
lymphoma here at this point if it occurs at the central blast stage this can give you two different types One is burkett's lymphoma and the other one is diffuse large B cell lymphoma so here at this point here we talked about I can give you what's called mantle cell lymphoma Perkins lymphoma diffuse RGB cell lymphoma now burkitt's lymphoma it's at the central blast stage this is due to a chromosomal translocation between eight chromosome 8 and chromosome 14. and what it does is It increases the expression of a very specific nasty molecule called cmyc and this
is basically a super hyperactive kind of proto-onco gene and when you hyperactivate this puppy this causes massive cellular proliferation so it'll cause the cells to proliferate very very quickly and you will increase the number of your cells very rapidly the big thing to remember with this Is that there's believed to be some type of trigger associated with this one especially especially Epstein-Barr virus and HIV this these patients who have birken lymphoma especially the African so there's different types there's the African population and then there's the ones that are in the non-african population in the African
population EBV HIV positive patients have a high risk of burkitt's lymphoma it may kind of increase the activity of this Chromosomal translocation the next one is diffuse large B cell lymphoma this one is the most common so I want you to remember one thing this is the most common type of Non-Hodgkin's lymphoma so out of all the B cell types of lymphoma this is the most common type of Non-Hodgkin's lymphoma and the reason why is I didn't talk about it but diffuse large B cell lymphoma it can occur here at the central blast stage it
Can also occur here it's called the Plasma Blast stage and it can occur at other areas as well but it is the most common one but what I want you to know about this one is there's no specific chromosomal translocation we just know that on chromosome number three on chromosome number three there's this increased expression of a very specific molecule called bcl6 I know I've hit a lot of these so Follicular was bcl2 marginal Zone was bcl10 diffuse large B cell lymphoma is bcl6 and I I know this sounds crazy like why do I need
to know this it's going to come in play when we get into the Diagnostics again so we'll recap this as well then because I know it's probably getting a little tough but if we increase the number of bcl6 what happens is it does the same thing it increases your cellular proliferation Acts like kind of a proto-onco gene type of activity and if you increase cellular perforation you will increase your cell number the thing is is that this is not the only one with diffuse large B cell formula there's actually thoughts that diffuse large B cell
lymphoma could be associated with increased bcl2 which caused inhibition of apoptosis there's other genes like the p53 gene that are believed to have a mutation in so there could be also associations not just with Bcl6 but if you want to add in here it may also affect things like bcl2 and p53 but remember that these are and high apoptotic genes so they basically will try to inhibit apoptosis and allow for the cell to continue to survive so you may have a combination of all these but I'd rather you remember specifically the bcl6 okay now another
thing to add on here is that diffuse large basal lymphoma has a very high association with EBV but especially Especially HIV positive patients so these are another thing that these mutations may be set affected by these particular viruses so again the big thing to remember for the rapid aggressive types of b-cell hot Non-Hodgkin's lymphoma type is that it could be due to mantle cell lymphoma mantle cell lymphoma is the cell that basically has no antigen exposure and sits in the mantle cell Zone but replicates replicates replicates because Of a 11 14 translocation which increases cyclin
D which increases cellular proliferation burkitt's lymphoma is a mutation that occurs in the central blast stage and diffuse large B cell lymphoma is a mutation that occurs in the central blast stage the difference is for burkets it's 8 14. which causes an increase in C Mick for diffuse it's chromosome 3 that increase the expression of bcl6 both of these Increase cellular proliferation I know that this is a lot of stuff that just happened here with Non-Hodgkin's and that's why it's a tough topic but now that we got a good idea at this point that this
is the most important one to remember you want to know why again we already talked about this a little bit but the B cell types of Non-Hodgkin's lymphoma account for about 85. to 90 percent of the Non-Hodgkin's lymphomas So if you remember these you'll remember most of the different types of Non-Hodgkin's level and if you had the extra space don't forget about that rare type of T Cell Non-Hodgkin's level which may be secondary to human T lymphotropic Virus you know how you get that this actually could be a high yielding IV drug abuse so don't
forget that as well but now that we've talked about this lymphocyte pathway and then the causes of how we get all these different types Of neoplastic lymphocytes now let's talk about what are the effects of having all of these neoplastic lymphocytes in the lymph nodes extranodal tissues are all over the body let's get into it all right my friend so now we have a patient who we suspect has Non-Hodgkin's lymphoma right when we think about Non-Hodgkin's lymphoma we have to understand that there is a ton of these neoplastic lymphocytes whether whether it is mantle cell
lymphoma whether it's Burkets whether it's a patient who has diffuse large B cell lymphoma marginal Zone lymphoma whatever it may be at these points they oftentimes present with these classic features because they're just proliferating or they're not dying in the lymph nodes so whenever that happens they just fill up these lymph nodes whether it be because of decreased apoptosis or increased cellular proliferation now when that happens you get these big Old lymph nodes now so you end up with something called lymph adenopathy so these big old plump lymph nodes and oftentimes they are painless which
is really really important to remember they are robbery generally but here's the big difference between Hodgkin's and Non-Hodgkin's because both of these can present with lymphanopathy oftentimes it is non-contiguous that is actually pretty important to Remember and the reason why is is if you guys go back and think about and we talked about patients who have Hodgkin's lymphoma it was contiguous so in other words if it started a point here it would move to the next one the next one the next one the next one if it's not Hodgkin's this thing can go from here
to here to here it can go wherever it wants it doesn't continue down the chain of lymph nodes it just moves all over the place that's super High yield my friend so I need you to remember that for Non-Hodgkin's lymphoma they have a lymphadenopathy but one of the key things here is that it is non-contiguous now what are the areas that are usually affected it tends to be the same kind of area cervical superclavicular maybe some axillary sometimes the mediastinal but the media style is way more common in Hodgkin's lymphoma but they can also involve
some of the abdominal lymph nodes as well so Watch out for some abdominal lymph node involvement as well so you can see these same kind of thing you can see cervical you could see superclavicular you could see axillary and you can see mediastinal but again I want you guys to remember that the mediastinal I want you to associate that more commonly with you see this more in Hodgkin's lymphoma than you will in Non-Hodgkin's level and Lastly you can even see abdominal and that's something that you don't really see in which one you don't really see
that in Hodgkin's lymphoma so with this one you'll see way more commonly a Non-Hodgkin's lymphoma than you will in Hodgkin's lymphoma so really really important to remember that now I have lymphadenopathy painless rubbery non-contiguous can also involve the abdominal lymph nodes which is not Common in Hodgkin's lymphoma that's the big thing so far the other things is when we talked about the alcohol-induced lymphadenopathy kind of pain you don't see that a Non-Hodgkin's lymphoma so that's another big thing but one of the other things that you want to remember is that these actual lymphocytes are releasing
some degree of cytokines things like interleukin-1 interleukin-6 tumor necrotic Factor Alpha to that effect these are hitting the hypothalamus and then the good old hypothalamus says okay time to go ahead and increase the body's temperature so it causes things like fevers causes things like night sweats and it also Alters things like appetite and can cause weight loss these are features of something called b symptoms so you can see these are what we refer to as something called b symptoms one of the big things to Remember is like oh wait Zach now I'm kind of losing
my mind here I'm kind of getting confused because lymphadenopathy was common in Hodgkin's lymphoma I get that it's contiguous in Hodgkin's non-contiguous and Non-Hodgkin's b symptoms are are also present in Hodgkin's lymphoma and not Hodgkin's yes but one thing to add on here is that b symptoms tend to be more common in Hodgkin's lymphoma than in Non-Hodgkin's lymphoma so we're starting To cite some kind of differences lymphanopathy in both of them contiguous and hot hot not hot contiguous and Hodgkin's non-contiguous and Non-Hodgkin's you see mediastinum more common in Hodgkin's you see abdominal more common in
Non-Hodgkin's b symptoms is present in both but it's more common in Hodgkin's lymphoma all right my friends so now we have a patient who comes in they have lymphadenopathy particular areas that we already Discussed painless rubbery non-contiguous meaning it doesn't spread in a continuous manner you may have one here and then one all the way over here right or one over here and then one over here so it doesn't spread in a continuous manner from lymph node to lymph node now the next thing is it it loves to involve external tissues way more than Hodgkin's
lymphoma does remember we said astronautal involvement way not like very like uncommon in Hodgkin's lymphoma right but it is super super common in comparison to Hodgkin's lymphoma so that's why I mentioned it there but understanding that it is way more common in this particular process so what happens is you have these kind of like lymph node kind of tumors if you will and what they do is they decide to get into the bloodstream so here you have these big chunks of lymphoplast like a neoplastic lymphocytes and they decide to get into the bloodstream Or spread
via other lymphatic tissues when they do that maybe some of the areas that they decide to go and wreak havoc on is the central nervous system and maybe some of these will deposit into the brain and if they deposit into the brain they cause something called primary CNS lymphoma and this is very important to remember that if you have a patient who's HIV positive very very high risk for this One and you can see this the most common presentation is diffuse large B cell lymphoma usually this is the one that has the most incidence of
primary CNS lymphoma especially if the patient is HIV positive the other thing is it can actually deposit not not only cause this tumor but it can even deposit into the meninges and it may cause things like meningitis it may even cause things like seizures As well but one other thing it also can deposit around the spinal cord so if it deposits around the spinal cord watch out for spinal cord compression and maybe the way that they present is in something like a Kata Aquinas syndrome so watch out for Kata aquina syndrome this could be one
of the reasons why as well that they present oftentimes when patients who have Non-Hodgkin's lymphoma sometimes the way That they present is due to oncologic emergencies so things like spinal cord compression or seizures or primary CNS lymphoma all right the next thing is what if it actually infiltrates into the bone marrow so now you get these kind of like neoplastic lymphocytes and they deposit into the bone marrow where you're supposed to be making a bunch of other blood cells if this deposits into the red bone Marrow then you actually make less space so if it
deposit into the red Bomer it decreases the space for other cells and now I get less production of oh my poor red blood cells they start dropping my poor platelets they start dropping and maybe even other different types of white blood cells like neutrophils potentially start dropping as well so then you get effects of pancytopenia which is decreasing level Of all cell lines so watch out for pan Saito Pina and this may present with the patient having if they have less red blood cells maybe anemia so they may present with fatigue or Pal or dyspnea
if they have less platelets they may present with bleeding or bruising if they present with neutropenia they may present with infections so these are things to watch out for okay The other thing here is it can and this is the interesting one T Cell all right so T cell lymphoma T cell lymphoma those T cells they love the deposit into the skin so in patients who have what's called this is actually called mycosis fungioides and this is basically you have a bunch of neoplastic T cells that are accumulating in this tissue and what they do
is they Form these like nasty like little plaques so they form these skin lesions they look like they're literally called plaques they look like a fungus they literally kind of look like these like nasty red fungal infection kind of appearances so they'll present with a lot of plaques what happens is and sometimes these actual T cells can spread into the bloodstream and when they spread into the bloodstream they Take on this like weird like shaped T cell and they're called cesari cells cesari cells and these cesari cells will go and deposit into the skin of
the tissues around the body and when it does that it causes this intense red rash that can occur all over the entire body a very diffuse rash this is called cesari syndrome this is called cesari Syndrome and they can literally develop what's called erythroderma so this is called erythro Derma it's a diffuse red rash and basically this is a feature of a T cell lymphoma so this is a type of manifestation that you may see in T cell lymphoma all right that's an important thing to remember so for T cell lymphoma look for specifically any
evidence of skin Plaques nasty skin plaques or very diffuse red rashes that can appear over the body and it's usually called cesari syndrome because you have these like cells called cesari cells that are circulating the blood and kind of depositing all over the skin in different areas of the body okay so so far it deposited into the CNS it deposit into the bone marrow it deposits into the skin and causes this weird situation here Another thing that can happen is it can deposit into glands so if it deposits into these things these glands these are
like let's say that these are your salivary glands and lacrimal glands or if it deposits into the thyroid gland you can have a lot of problems here so now imagine I get a clump of these lymphocytes these neoplastic lymphocytes that accumulate here and these areas here now I can start seeing decreased like saliva I can start seeing decreased what else maybe lacrimal fluid and so you can end up with dry eyes and dry mouth so this is a really really important thing to remember because sometimes this is associated with Sjogren's syndrome okay the next one
here is the thyroid tissue the thyroid tissue can actually deposit into the thyroid tissue and cause an enlarged thyroid so it may cause thyro Megaly now a big thing to remember here big big thing to remember here is that usually if these neoplastic lymphocytes deposit into the salivary and lacrimal glands or into the thyroid gland if you see these this is commonly associated with what's called marginal Zone lymphoma all right marginal Zone lymphoma let's actually do that in Black here and then we'll highlight it up but if you see an involvement of the Salivary and
lacrimal glands and the thyroid gland this is commonly associated with marginal Zone lymphoma and if you guys remember marginal Zone lymphoma was one of those lymphomas that was usually due to an increase in BCL 10 expression we'll talk about this a little bit later but when I didn't discuss it before but bcl10 expression those kind of like cells when they produce lots of bcl10 One of the things that actually could be due to like a chronic inflammation so if patient had an infection like H pylori or if they have like sjogren syndrome or Hashimoto thyroiditis
this can definitely cause marginal Zone lymphoma because it causes a lot of inflammation which may cause mutations and increase the expression of bcl10 as we talked about before another one is that you can kind of get these neoplastic lymphocytes the deposit Into the actual stomach and this can cause what's called gastric malt lymphoma and this is also extremely common and patients who have marginal Zone lymphoma so marginal Zone lymphoma can be associated with gastric malt lymphoma thyroid kind of enlargement and salivary and lacrimal gland kind of infiltration and so that's a really really important Thing
so think about marginal Zone lymphoma and patients who have a history of peptic ulcer disease so think about this in a patient as a history of peptic ulcer disease who has Hashimoto's or has chagrance very very high yield because these are the things that are actually causing the increase in bcl10 okay next thing Is we could deposit these lymphocytes into an area of the small bowel you know there's an area of the small bowel here called the ilio SQL valve and what happens is if we deposit onto the ileocecal valve it thickens the ileocecal valve
and if you thicken the ileocecal valve if I thicken the ileocecal valve that can cause cause A small bowel obstruction that's another thing that you can potentially see we usually see this in patients who have what's called burkets lymphoma but the sporadic type so this is usually seen What's called the birkett's lymphoma the non-african type or the sporadic type okay so remember burkets lymphoma for ileocecal valve involvement the other thing is we can have some of these neoplastic lymphocytes deposit Into the liver or deposit into the spleen and they will cause the enlargement of the
spleen and the liver so we can call this hepato spleno megaly and this may present in a lot of different ways maybe it presents with abdominal fullness maybe it presents with nausea vomiting anorexia but you're going to have something like this and this is very commonly seen with Different types of lymphomas maybe even follicular lymphoma so you may see this with the follicular type or really all different types of Non-Hodgkin's lymphoma but one of the times that we see like a lot of it is is in follicular lymphoma so follicular lymphoma watch out for any
evidence of hepatosplenomegaly okay now with that being said I talked about a lot of different things there's one More thing that I want you guys to remember with the bone we talked about how if it can infiltrate into the bone marrow right let's say I put one more kind of thing here so let's say I bring back another diagram of the bone we can actually deposit these lymphocytes into the bone but more specifically the bones of the jaw so if these kind of neoplastic lymphocytes deposit into the bone let's Put bone of the jaw it
can cause a very enlarged mass of the jaw and this is a really sad thing here so what we can see is we can see a very large jaw Mass and this is common in a patient who has the burkitt's lymphoma the endemic or African type so I want you guys to remember that this is seen in burkets lymphoma but more specifically the African subtype the one that's associated with Epstein-Barr virus or HIV positive patients okay so from this point my friends patient comes in they have maybe some painless robbery non-contiguous lymphadenopathy cervical superclavicular axillary
abdominal not as common in the mediastinal maybe they have some mild b symptoms and then they come and they present with things like thyroid enlargement maybe Decreased salivary and lacrimal gland production they have a history of Sjogren's they have a history of Hashimoto's they also come with like abdominal pain because of a lot of gastric Invasion this could be seen with which type marginal Zone lymphoma if I said okay I have a patient who has primary CNS lymphoma maybe meningitis seizure spinal cord compression this could be due to diffuse large B cell lymphoma If I
were to say okay I have one that's actually infiltrating into the bone around the Maxwell and the mandible the jaw caused a big old large jaw Mass this is birkenstone from which type African or the sporadic African associated with which things EBV and HIV if I said that it also could involve the things like the skin and cause these nasty skin plaques that look like fungal infections maybe even gets into the bloodstream like a leukemia type spreads All over the area and causes diffuse redness over the body this can be seen with T cell lymphoma
and then again if I said that there's involvement of the ileocecal valve it causes thickening of it and causes a small bowel obstruction this is associated with burkett's lymphoma the sporadic type not associated with HIV and EBV and then if I also said hepatosplant omegaly you would see this with Liquid lymphoma so these are the things that I want you to remember now before we go on one of the other things I want you to understand here is some complications that you can see in Non-Hodgkin's that you don't really see in Hodgkin's lymphoma one of
the big things here is that sometimes when you get these big old tumor masses if you get like a really really heavy tumor burden these tumor Burdens may increase the expression of an enzyme called one alpha hydroxylase you know what that does that increases the vitamin d and vitamin D increases your blood calcium levels so one of the things that you want to watch out for is that sometimes these patients can have hypercalcemia but the hypercalcemia is due to the lymphoma the other thing that you want to watch out for is that in situations where
you Have a high tumor burden the tumor cells rupture and if they rupture they spill out a lot of different types of molecules like potassium they spell out things like phosphate they spill out things like uric acid and then because of this and then they have low calcium because of this the specifically the uric acid and then the calcium phosphates these specific things go to The kidney and they damage the kidney and cause an acute kidney injury this can cause acute kidney injury what is this called here this is when the tumor cells rupture our
lice this is called tumor lysis syndrome so you can also see this as another potential complication called tumor lysis syndrome so you can see tumor Lysis syndrome as one potential complication let's actually write this here so tumor cell let's actually write like this lysis because of lots of tumor burden so tumor cell lysis you could have tumor lysis syndrome which can cause an acute kidney injury or you can have lots of activation of vitamin D which causes hypercalcemia these are the things that I really want you to remember my friends now we still Got the
half of the board left to do we have a patient that we think has Non-Hodgkin's lymphoma because of the lymphadenopathy the possible b symptoms extra nodal tissue involvement maybe they present with neural features maybe they present with other potential things like relating to the git like abdominal pain or nausea vomiting maybe they present with hepatosplenomegaly maybe they also present with pancytopenia with features of pancettopenia maybe they Present with a large jaw Mass maybe present with some skin lesions all right or they present with like a thyroid enlargement or maybe even some type of problem with
their salivary and lacrimal glands if that's the case you should start thinking about Non-Hodgkin's and think about the potential complications such as hypercalcemia and tumor lysis syndrome at this point we now need to diagnose Non-Hodgkin's lymphoma all right so we have a patient we think has Non-Hodgkin's lymphoma they come in they have some potential evidence of lymphadenopathy they maybe have some extra noodle features maybe some b symptoms but you're definitely seeing some lymphanopathy and that's going to be one of the common features and again this could be cervical superclavicular axillary abdominal less common media style
but if it is mediastinal look for that compressive symptoms right so maybe they have things like shortness of Breath or coughing due to compression of Airways in pleura or maybe they have compression of the pericardium causing some degree of chest pain they have superior vena cava syndrome so think about that as well but regardless if they have any lymphadenopathy with some plus or minus some b symptoms think about taking a look at that lymph node because what you want to figure out is you want to know Is this Mets so is this lymphadenopathy is this
lymphadenopathy secondary to Mets versus lymphoma now once you've done that you do the lymph node biopsy the lymph node biopsy will then show you okay is it Mets if it is you're done so is there's Mets that's our pop Mets are positive okay then it's metastatic cancer it came from somewhere else go looking for that is there Reed Sternberg sells or variants like popcorn cells if that's present then you're done okay then it's Hodgkin's lymphoma right and it's not this disease it's not Non-Hodgkin's but if you do this lymph node biopsy and it shows negative
Reed Sternberg cells or negative popcorn cells and negative evidence of Mets than it is likely Non-Hodgkin's lymphoma And that's the step that we would go with the question then comes though is this T cell or is this B cell that's the question I don't know which one it could be it's likely 85 to 90 of the time it's likely B cell but I got to figure that out so this is really what the lymph node biopsy will do is it'll get me to the point of determining okay is it Mets Hodgkin's or Non-Hodgkin's then I
go to the next part which is flow Cythometry so once I've done this part here and I say okay I found out that I have some neoplastic cells here so here's my neoplastic lymphocytes but my question is here is I know that this is Non-Hodgkin's lymphoma is it B or t not Hodgkin's lymphoma so then that's where I have to kind of take a look specifically at the different types of cluster differentiation proteins because that's where it differs So if I have cluster differentiation proteins on this cell and I have cluster differentiation proteins on this
cell they should differ in some degree so if this is let's say CD 3 positive and this is CD 20 positive for the CD3 positive this suggestive of the T cell Non-Hodgkin's lymphoma if it's cd20 positive it's suggestive of The B cell Non-Hodgkin's lymphoma right so at that point utilizing flow cytometry I can delineate which type it is now if it's the T cell type then we know that it's probably some degree of T cell lymphoma right and we're not going to go crazy down that rabbit hole but what we will focus on since 85
to 90 percent of the cases are usually B cell lymphomas is now we have to go to this next part Oh it came back B cell Non-Hodgkin's lymphoma well then I gotta know is it mantle cell lymphoma is it diffuse large B cell lymphoma is it follicularly lymphoma or burkett's lymphoma is it follicular lymphoma or is this marginal Zone lymphoma how do I tell which one it is because for T cell type obviously I look for it specifically you know how I can actually tell for T Cell specifically it likes to Involve skin lesions so
I actually take skin biopsies so oftentimes you'll do a skin biopsy for the T cell lymphoma especially for the mycosis fungios and you'll see these things called poutriers micro abscesses and then if you look those T cells they get into the blood if you do a blood smear you'll see those cells called cesari cells so that's kind of how I could look for the mycosis fungios and the T Cell kind of lymphoma But for this one I gotta go a little bit further because now I got to figure out okay I remember mantle cell that
was like a mutation right so this was the which one do you guys remember so he said this was the 11 14. translocation diffuse was the increase in BCL 6. burketts was which one this was 8 14 translocation so this is the eight 14 translocation and then for follicular it was a 14 18 Translocation and then for marginal cell this was a increase in BCL 10. and the big thing I said here is that oftentimes diffuse large B cells the most common associated with HIV Epstein-Barr Burke gets associated with Epstein-Barr and HIV especially the African
type and then marginal Zone lymphoma is oftentimes associated with Hashimoto's chagrins or peptic ulcer disease caused by H pylori But that's not enough I gotta actually find these specific problems and look at it so let's come down for a second and talk specifically about the cytogenetics and how we actually can look for these chromosomal translocations how we can identify the specific Fusion genes on the PCR and then also how we can actually look at these under the microscope so if we come down here I'm going to take in this chunk of tissue and look at
it and I'm Going to be able to say okay let's not read Sternberg cells that's not popcorn cells that's not metastatic cancerous cells this is Non-Hodgkin's lymphoma cells and then I've already delineated okay this is a B cell type of Non-Hodgkin's lymphoma what I want to do next is once I've said okay these are cd20 positive cells I want to know where is the actual chromosomal abnormality so then what I do is as I take the genetic material Here so I'm going to take the genetic material and I'm going to look at the chromosomes that
are involved and I'm going to look if I actually kind of find oh here's that particular kind of translocation or here's that mutation then what I'll do is I'll string out the actual DNA there and look for the specific Gene that's the problematic issue here and I'll quantify that so I use cytogenetics to Find the chromosomal translocation and PCR to find the specific Gene and quantify it now it was easy because we said we could differentiate the B cell types based upon the ones that are slow growing very indolent because they have decreased apoptosis that
was which one let's see if you guys remember it was follicular lymphoma and marginal Zone lymphoma here Just for easy uh abbreviation purposes follicular lymphoma marginal Zone lymphoma for follicular lymphoma what was the chromosomal abnormality it was 11. 14. translocation the 1114 produced what specific molecule increase in bcl2 and the bcl2 is what led to a decrease in apoptosis so I would use the cytogenetics to find that translocation and use PCR to quantify this Gene that's Overexpressed for marginal Zone lymphoma look for this to be associated with peptic ulcer disease Hashi motos or chagrance that
is really high yield here look for thyroid salivary lacrimal gland involvement or history of peptic ulcer disease for this one there's no specific Gene but what we know is that we do PCR we find the increased expression of BCL 10. and that is the problem here that when We do that on PCR so so far I've been able to delineate this based upon chromosomal translocation for follicular this in the history the peptic ulcer Hashimoto chagrance which led to a increased expression of bcl10 and then for the types with increased cellular proliferation which are the rapid
aggressive types what were these three there was mantle cell lymphoma There was burkett's lymphoma and there was diffuse large B cell lymphoma if you guys remember this was of these centrocytes this was of the marginal Zone cells this was of the mantle cells and these were of the centroblasts for the mandal cell lymphoma this was which one this was going to be associated with for this one actually follicular I apologize this should be 14 18. this should be 14 18. The mantle cell lymphoma should be 11 14. so this should be 11 14 translocation and
what this does is this increases the expression of cyclin d and if you increase the expression of cycling D that will increase cellular proliferation so if I go through I do the cytogenetics I'll find the 1114 translocation and then if I do the PCR I'll find the increased expression of the cyclin D Gene For burkett's lymphoma I'm going to find an 8 14 translocation and that will lead to an increase in what what specific molecule the C mcgene so C NYC Gene and that causes excessive cellular proliferation so I would do the cytogenetics to find
this chromosomal translocation and I would do the PCR to quantify that particular Gene and then the last thing or also added on Here Birch lymphoma you can have sporadic which is non-ebv non-hiv associated or you can have the endemic African type which is EBV HIV presence same thing for diffuse large B cell lymphoma it's heavily involved in EBV and HIV but for this one there's no specific true and translocation it's just chromosome number three increases the expression of B CL 6. And with the increased expression of bcl6 we get increased cellular proliferation so ways that
we can determine which B cell type it is so we've said okay it's the B cell which one is it we kind of go to this next step here and we say okay let's look at the cytogenetics let's look at the PCR that may be able to elucidate the obvious ones like for liquid lymphoma with the 1418 or we May be able to recognize the mantle cell with the 1114. and burkets with the 814 and then we can use PCR to find the specific genes for the other ones like marginal Zone and diffuse large b-zone
foam which there's no obvious chromosomal translocation you may be able to use PCR to find the expression of these increased expression of these genes but other ways that we can determine this is by looking at histopathology so We can look at these genes but we can also look at the histopathology and so what I want you guys to do here for a second is take a look at what does follicular lymphoma histopathology look like it looks like this what does marginal Zone lymphoma's histopathology looks like it looks like this what does mantle cell lymphoma's histopathology
look like it looks like this What does burkett's lymphoma histopathology look like this it looks like this it's also really important to remember that oftentimes we call that the Starry Sky appearance for birken symphoma and lastly if we look at the histopathology of diffuse large B cell lymphoma it looks like this so at this point we have taken a patient who we had lymphadenopathy for we discerned that they had Non-Hodgkin's Lymphoma based upon the biopsy we determine if it was b or T cell with flow cytometry and then we use cytogenetics and PCR and histopathology
to determine the type of B cell Non-Hodgkin's lymphoma they have once we've done that we then can say Okay has it spread to areas of the body that we don't want it to like extra nodal tissues how do I determine that let's go talk about that I'm a friend so now we move on to the staging so we have Diagnosed Non-Hodgkin's lymphoma specifically whatever type it may be off of what we just discussed at this point we have to determine okay has it spread to extranodal tissues and again it's important to go back I know
it was a lot of stuff but did it spread to areas of the git so that gastric malt lymphoma that is spread through the thyroid the salivary glands all of those three were associated with which one marginal Zone lymphoma Then I spread that a bone marrow so and pretty much any type can spread to the bone marrow but it also did it spread to the bone of the jaw like the maximum of the mandible that's associated with burkets did it spread to the actual brain that's associated with the free stars b-cell and foam especially if
they're HIV positive did it spread to other areas like this spleen the liver which you can see in follicular lymphoma prominently so you get the point has it Spread to other areas of the body how do we determine if it did do that we can do something called a PET CT scan and what we do is we give the patients and we take we're assuming that this has gotten to the blood and then from here it's spread to multiple different areas of the body we're deposited into the liver it deposit into the spleen the git
maybe even to the pleura the pericardium which you can also see as a potential complications if it's spread into the Plural what could you get plural effusions if it's spread into the pericardium you can get pericardial effusions you can even get tamponade potentially it's rare but it's possible if that happens I want to know how did it how can I discern if it spread a PET CT scan where I use something called fluorodeoxy glucose will light up all the areas that the tumor cells have spread to another alternative that you can do here Is I
could do something called a CT of the chest abdomen and pelvis with contrast particularly IV contrast and that'll also light up these areas but these are the two particular tests that I would want to consider to look to see if it's spread to other areas of the body besides the brain and the bone marrow if it spread to the central nervous system I first want to see is the patient HIV positive And do they have any neuro deficits or symptoms if they do I want to do a MRI of the brain and I want to
do an LP of the actual cerebral spinal fluid to see if I can find those neoplastic lymphocytes so that's another thing that I would want to consider is an MRI to look for any primary CNS lymphoma or an LP to look for any meningitis or any invasion of the meninges and this cerebral spinal fluid The other thing is I want to know didn't invade the bone marrow so one of the ways I can invade the bone marrow is I could see pancetta penis so dropping all the cell lines but I could also just take a
bone marrow biopsy and if I do a bone marrow biopsy I would find all these different types of neoplastic lymphocytes so a bone marrow biopsy so these are the ways that I can determine if it's spread to other areas of the body so in other words is There extra nodal involvement okay now at this point we can then say okay I've determined which I've determined if it's Non-Hodgkin's if it's b or t which type of B cell it is and then I determine if it has extraordal involvement from there I can stage this patient I
can use something called the and Arbor staging system when we use this system what we do is we Have stage one two three and then the last one oh man you're never going to be able to guess this one guys it's stage four but that was a big shocker but with all of these stages we have lymph node involvement so if there is maybe one lymph node region here that's stage one if there's maybe two plus lymph node regions but they're on the same side of the body this is stage two or that's I'm sorry
on The same side of the diaphragm if there's stage three it's two plus lymph node regions but maybe they're involved in both sides of the diaphragm so now I have both sides of the diaphragm and then stage four is I have two plus lymph node regions they could be anywhere they please right so they could be on both sides they could be on different sides but I also have Extra nodal involvement so maybe the liver maybe I have it of the spleen let's just draw the spleen in there as well but you get the point
there's been invasion of other areas if there's invasion of other areas that's extra nodal involvement and that is stage four at this point that'll help me to determine which is their stage but then I add on a subclassification system so There's also a sub classification so a sub classification and I'll give you guys an example here in a second but what we do with this one is we kind of divvy this out into three parts a b x so a is the absence of b symptoms B is the presence of b symptoms and X is
the presence of bulky disease what the heck does that mean so the presence of bulky disease mean you get like a tumor in one of the lymph Nodes and that sucker is greater than 10 millimeters or I'm sorry 10 centimeters so if it's a it's negative B symptoms B is there's positive b symptoms you guys remember what the b symptoms were fevers night sweats weight loss not as common with Non-Hodgkin's though and then X is you have a lymph node that's greater than or equal to 10 centimeters this is bulky disease so let's give you
an example to kind of make sense of this here I have a patient who has Non-Hodgkin's lymphoma they have two lymph node regions that are present on both sides of the diaphragm okay if it's on both sides of the diaphragm that's three the next thing is we also move on to say okay with a lymph node that is so they actually have amb symptoms oh okay so this is stage three let's actually write this out stage three why is it stage three two lymph node regions on both sides of the diaphragm B symptoms that's B
with a lymph node that is approximately 15 centimeters in diameter and involvement of the spleen of the bone marrow we got to come back now so it's not three and you want to know why it's not three I have extra nodal involvement spleen bone marrow involvement so that's actually stage four so this is stage four Presence of b symptoms B and the lymph node size is approximately 15 centimeters that's greater than 10 centimeters BX oh that's a terrible stage so that's stage four BX for this patient who has Non-Hodgkin's lymphoma at this point we have
diagnosed Non-Hodgkin's lymphoma we've been able to Stage it now the reason why we need to know how to Stage it is because it determines how aggressively we'll treat These patients let's talk about the treatment all right my friends we finally made it to the treatment now the treatment for Non-Hodgkin's lymphoma thank goodness it's relatively straightforward remembering like Hodgkin's there was the two alternatives to like stage one stage two you would do the abvd the adriamycin also known as Dr Robison bleomycin the ven Christine and you would also do things like procarbazine and then if they
maybe had Stage three four we could repeat that six times or we could do the be a cop regimen the bleomycin the atopocide Again The Atrium icing also known as doxorubicin we had the cyclophosphamide the oncovin also known as Vin Christine prednisone and then again we had the the other option there which is the procarbazine now in these particular scenarios it's actually one regimen for the most part you start off with systemic chemotherapy For regardless of which type of you know Non-Hodgkin's lymphoma that you have now with the exception I'm going to put like a
little kind of like a posture or like a hyphen here R chop is the mnemonic so it's abvd for stage one two Hodgkins and then be a cop for stage three four Hodgkin's for Non-Hodgkin's it's our chop okay so this is for rituximat but I got to be really particular because rituximab is a it's a great drug to give but the patient has To be cd20 positive B cells in other words this has to be a very specific type of B cell lymphoma that has to have cd20 positive cells because it's targeting that cd20 so
that's one particular option the next one is C so this is going to be for cyclo phosphamide cyclophosphamide the other one is H so this is actually hydroxy Donna rubison or it could also just be donorubicin There's another one which is called ankovan but remember ankovan is the brand name the actual generic name is called vincristine and the last one here is actually going to be prednisone but it's important to remember that this can be prednisone but it can be really any type of steroid prednisolone dexamethasone you just want to remember that it's going to
be steroids in the regimen this would generally be the regimen that you would Puts on for someone who has Non-Hodgkin's lymphoma and hopefully it'll kill those actual lymphocytic cells now The Next Step here is intrathecal chemotherapy whenever a patient who has Non-Hodgkin's lymphoma is HIV positive so if they are H IV positive or they have primary CNS lymphoma we should do intrathecal chemotherapy whether it Be prophylaxis if they're HIV positive or whether they actually have the disease generally an intrathecal chemotherapy what we do is we can do this via like a lumbar drain or we
can do this via kind of like a catheter here we're squirting into the ventricles into the cerebrospinal fluid something called intrathecal methotrexate so we use something called intra Fecal methotrexate and again this is specifically because one of the potential problems that we worry about with Non-Hodgkin's lymphoma is not Hodgkin's lymphoma especially which type diffuse large b-cell lymphoma May potentially spread to the brain and cause this primary CNS lymphoma this tumor here so that's one of the big big fears that we have to have with this particular disease Okay so intradigal chemotherapy again we would do
this as a prophylaxis in HIV positive patients or if they have primary sinus lymphoma because again you can see this with spreading of diffuse large B cell lymphoma into the brain so the last one here is marginal Zone lymphoma so marginal Zone lymphoma what I really want you to remember is is that this was associated with which three disorders one is you can see this in peptic ulcer disease which is secondary To H pylori you can see this in Hashimoto's and you can also see this in Chagrin syndrome so these were autoimmune diseases so you
can see this in autoimmune diseases and you can also see this in peptic ulcer disease due to H pylori remember in these you could have Hashimoto's and thyromegaly chagrance you could have a lot of lacrimal salivary gland involvement as well and Lymphocytic kind of in deposition here with this one you can get gastric malt lymphoma this is the really big one so this is the big one I want you to think about sometimes you can get these neoplastic lymphocytes that accumulate here due to lots of inflammation because basically you get a lot of inflammation and
these diseases the inflammation then triggers an increase in the expression of BCL which one you guys remember 10. And that basically led to the evasion of apoptosis so if you guys remember that led to inhibition of apoptosis so you probably think oh this patient's got to get chemo actually it's really weird it's one of the few where if you treat their underlying disease if you treat their H pylori in other words the cause is the inflammation and the inflammation is Being caused by this dang bug here the H pylori if I eradicate the H pylori
I eradicate the inflammation I eradicate this hyper expression of bcl10 and I eradicate apoptosis and I prevent this gastric malt lymphoma so again this all leads to what's called a gastric malt lymphoma how do I treat H pylori do you guys Remember we would give them clarithromycin you're like wait I'm giving antibiotics to a cancer yes and then you're also giving amoxicillin because if you treat the actual problem here you can break you prevent this continuous actual uh apoptotic pathway from being inhibited and prevent the actual progression of gastric malt lymphoma so this is one
of those rare situations so it's important To be able to remember that also if you guys want to remember this is technically part of the cap therapy you don't need to know this but also because you get peptic ulcer disease you can put them on a PPI so we call this the cap therapy for h pylori but in this video my friends we have covered in detail Non-Hodgkin's lymphoma I hope it made sense I hope that you guys enjoyed it and as always until next time [Music] foreign [Music]